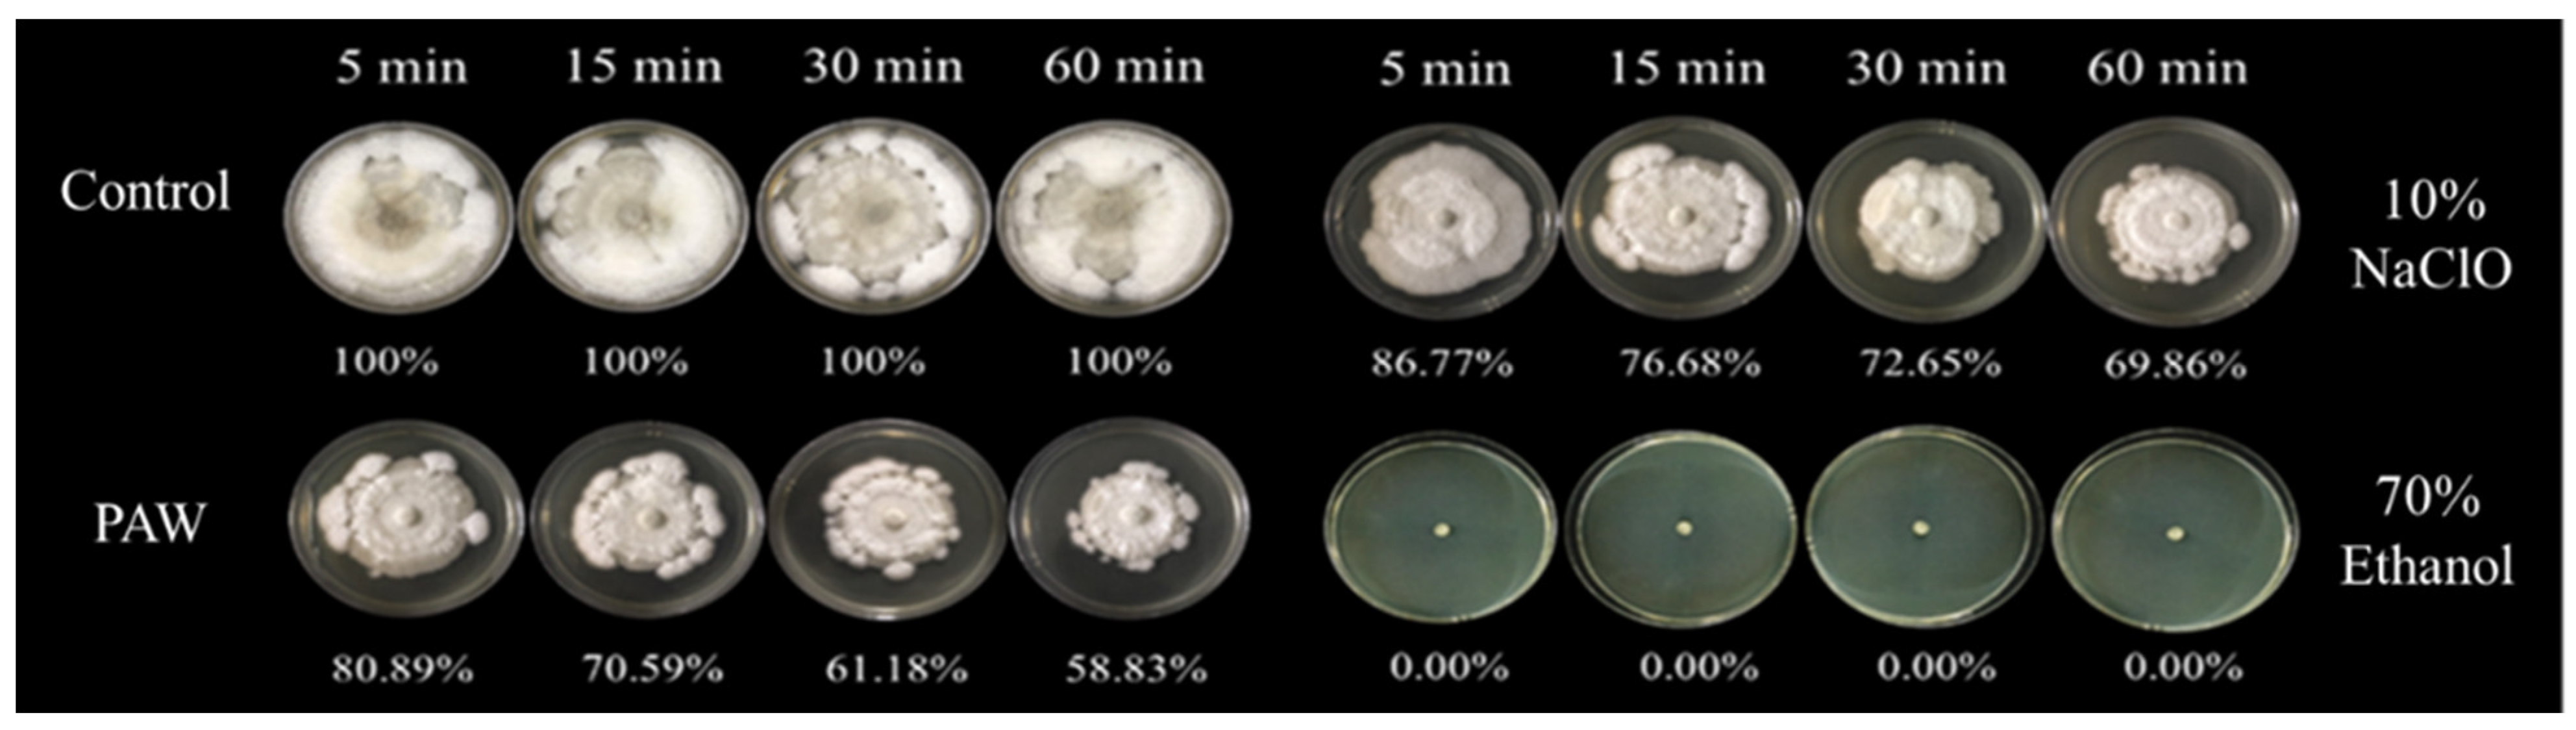
Foods 11 02859 g009 Foods 11 02859 g009

Application of Pinhole Plasma Jet Activated Water against Escherichia coli, Colletotrichum gloeosporioides, and Decontamination of Pesticide Residues on Chili (Capsicum annuum L.)
Abstract
1. Introduction
2. Materials and Methods
2.1. Materials, Chemicals, and Microorganisms
2.2. Plasma Activated Water (PAW) Preparation
2.3. Efficiency of PAW for Pesticide Elimination
2.3.1. In Solution
2.3.2. In Chili
2.4. Efficiency of PAW for E. coli Decontamination
2.4.1. In Suspension
2.4.2. In Chili
2.5. Efficiency of PAW for Decontamination on C. gloeosporioides
2.5.1. Mycelial Growth
2.5.2. Spore Germination
2.5.3. Anthracnose in Chili
2.6. Hydrogen Peroxide Measurement
2.7. Pesticide Residues Measurement
2.8. Statistical Analysis
3. Results and Discussion
3.1. The Efficiency of PAW for the Degradation of Pesticides
3.1.1. PAW Treatment for the Pesticides in Solution
3.1.2. PAW Treatment for the Pesticides in Chili
3.2. The Efficiency of PAW for Decontamination of E. coli
3.2.1. Decontamination of E. coli in Suspension
3.2.2. Decontamination of E. coli in Chili
3.3. The Efficiency of PAW for Inhibition of C. gloeosporioides
4. Conclusions
Supplementary Materials
Author Contributions
Funding
Institutional Review Board Statement
Informed Consent Statement
Data Availability Statement
Acknowledgments
Conflicts of Interest
References
- Tiffany. Hot Stuff: What Are the Different Thai Chilies? Available online: https://www.foodrepublic.com/2016/08/31/hot-stuff-what-are-the-different-thai-chilis/ (accessed on 20 April 2022).
- Thai-PAN. The Thailand Pesticide Alert Network. Available online: https://www.thaipan.org/highlights/2283 (accessed on 20 April 2022).
- Lacap, A.T.; Photchanachai, S.; Bayogan, E.R.V.; Wongs-Aree, C.; Pongprasert, N. Reduction of chlorpyrifos residues in ‘super hot’ chili (Capsicum annuum L.) fruit using washing agents. Philipp. J. Sci. 2021, 150, 237–244. [Google Scholar]
- Medina-Pastor, P.; Triacchini, G. The 2018 European Union report on pesticide residues in food. EFSA J. 2020, 18, e06057. [Google Scholar] [CrossRef] [PubMed]
- World Health Organization (WHO). Food Safety: Pesticide Residue. Available online: https://www.who.int/news-room/questions-and-answers/item/food-safety-pesticide-residue (accessed on 22 April 2022).
- Luna-Guevara, J.J.; Arenas-Hernandez, M.M.P.; Martínez de la Peña, C.; Silva, J.L.; Luna-Guevara, M.L. The role of pathogenic E. coli in fresh vegetables: Behavior, contamination factors, and preventive measures. Int. J. Microbiol. 2019, 2019, 2894328. [Google Scholar] [CrossRef] [PubMed]
- Diao, Y.Z.; Zhang, C.; Liu, F.; Wang, W.Z.; Liu, L.; Cai, L.; Liu, X.L. Colletotrichum species causing anthracnose disease of chili in China. Pers. Mol. Phylogeny Evol. Fungi 2017, 38, 20–37. [Google Scholar] [CrossRef] [PubMed]
- Sharma, M.; Kulshrestha, S. Colletotrichum gloeosporioides: An Anthracnose causing pathogen of fruits and vegetables. Biosci. Biotechnol. Res. Asia. 2015, 12, 1233–1246. [Google Scholar] [CrossRef]
- Manda, R.R.; Gopalakrishnan, P.; Addanki, V.A.; Srivastava, S. Anthracnose of Capsicum annuum L. (Chilli). Int. J. Curr. Microbiol. Appl. Sci. 2020, 9, 749–756. [Google Scholar] [CrossRef]
- Kiran, R.; Akhtar, J.; Kumar, P.; Shekhar, M. Anthracnose of chilli: Status, diagnosis, and management. In Capsicum; Dekebo, A., Ed.; Intech Open: London, UK, 2020. [Google Scholar] [CrossRef]
- Bhilwadikar, T.; Pounraj, S.; Manivannan, S.; Rastogi, N.K.; Negi, P.S. Decontamination of microorganisms and pesticides from fresh fruits and vegetables: A comprehensive review from common household processes to modern techniques. Compr. Rev. Food Sci. Food Saf. 2019, 18, 1003–1038. [Google Scholar] [CrossRef]
- Rutala, W.A.; Weber, D.J. Disinfection, sterilization, and control of hospital waste. Mandell Douglas Bennett’s Princ. Pract. Infect. Dis. 2014, 2015, 3294–3309. [Google Scholar] [CrossRef]
- Ntui, V.O.; Uyoh, E.A.; Ita, E.E.; Markson, A.A.; Tripathi, J.N.; Okon, N.I.; Akpan, M.O.; Phillip, J.O.; Brisibe, E.A.; Ene-Obong, E.E.; et al. Strategies to combat the problem of yam anthracnose disease: Status and prospects. Mol. Plant Pathol. 2021, 22, 1302–1314. [Google Scholar] [CrossRef]
- Gharibzahedi, S.M.T.; Hernández-Ortega, C.; Welti-Chanes, J.; Putnik, P.; Barba, F.J.; Mallikarjunan, K.; Escobedo-Avellaneda, Z.; Roohinejad, S. High pressure processing of food-grade emulsion systems: Antimicrobial activity, and effect on the physicochemical properties. Food Hydrocoll. 2019, 87, 307–320. [Google Scholar] [CrossRef]
- Clemente, I.; Condón-Abanto, S.; Pedrós-Garrido, S.; Whyte, P.; Lyng, J.G. Efficacy of pulsed electric fields and antimicrobial compounds used alone and in combination for the inactivation of Campylobacter jejuni in liquids and raw chicken. Food Control 2020, 107, 106491. [Google Scholar] [CrossRef]
- Dávila-Rodríguez, M.; López-Malo, A.; Palou, E.; Ramírez-Corona, N.; Jiménez-Munguía, M.T. Essential oils microemulsions prepared with high-frequency ultrasound: Physical properties and antimicrobial activity. J. Food Sci. Technol. 2020, 57, 4133–4142. [Google Scholar] [CrossRef]
- Ayodhya, C.; Veerabhadram, G. UV-light-driven photocatalytic degradation and antimicrobial properties of efficient ternary semiconductor CdxAg1–xS nanocomposites. Inorg. Nano-Met. Chem. 2020, 50, 43–56. [Google Scholar] [CrossRef]
- Sobol, Z.; Jakubowski, T. The effect of storage duration and UV-C stimulation of potato tubers, and soaking of potato strips in water on the density of intermediates of French fries production. Przegląd Elektrotechniczny 2020, 96, 242–245. [Google Scholar] [CrossRef]
- Sobol, Z.; Jakubowski, T.; Wron, P. The effect of UV-C stimulation of potato tubers and soaking of potato strips in water on density differences of intermediates for French-fry production. BIO Web Conf. 2018, 10, 2031. [Google Scholar] [CrossRef][Green Version]
- Jakubowski, T.; Królczyk, J.B. Method for the Reduction of Natural Losses of Potato Tubers During their Long-Term Storage. Sustainability 2020, 12, 1048. [Google Scholar] [CrossRef]
- Los, A.; Ziuzina, D.; Boehm, D.; Bourke, P. Effects of cold plasma on wheat grain microbiome and antimicrobial efficacy against challenge pathogens and their resistance. Int. J. Food Microbiol. 2020, 16, 108889. [Google Scholar] [CrossRef]
- Bangar, S.P.; Suri, S.; Nayi, P.; Phimolsiripol, Y. Cold plasma for microbial safety: Principle, mechanism, and factors responsible. J. Food Process. Preserv. 2022, e16850. [Google Scholar] [CrossRef]
- Gavahian, M.; Chu, Y.H.; Khaneghah, A.M.; Barba, F.J.; Misra, N.N. A critical analysis of the cold plasma induced lipid oxidation in foods. Trends Food Sci. Technol. 2018, 77, 32–41. [Google Scholar] [CrossRef]
- Misra, M.M.; Martynenko, A.; Chemat, F.; Paniwnyk, L.; Barba, F.J.; Jambrak, A.R. Thermodynamics, transport phenomena, and electrochemistry of external field-assisted nonthermal food technologies. Crit. Rev. Food Sci. Nutr. 2017, 58, 1832–1863. [Google Scholar] [CrossRef]
- Phan, K.T.K.; Phan, H.T.; Boonyawan, D.; Intipunya, P.; Brennan, C.S.; Regenstein, J.M.; Phimolsiripol, Y. Non-thermal plasma for elimination of pesticide residues in mango. Innov. Food Sci. Emerg. Technol. 2018, 48, 164–171. [Google Scholar] [CrossRef]
- Mousavi, S.M.; Imani, S.; Dorranian, D.; Larijani, K.; Shojaee, M. Effect of cold plasma on degradation of organophosphorus pesticides used on some agricultural products. J. Plant Prot. Res. 2017, 57, 25–35. [Google Scholar] [CrossRef]
- Sarangapani, C.; Scally, L.; Gulan, M.; Cullen, P.J. Dissipation of pesticide residues on grapes and strawberries using plasma-activated water. Food Bioprocess Technol. 2020, 13, 1728–1741. [Google Scholar] [CrossRef]
- Zheng, Y.; Wu, S.; Dang, J.; Wang, S.; Liu, Z.; Fang, J.; Han, P.; Zhang, J. Reduction of phoxim pesticide residues from grapes by atmospheric pressure non-thermal air plasma activated water. J. Hazard. Mater. 2019, 377, 98–105. [Google Scholar] [CrossRef] [PubMed]
- Albertos, I.; Martín-Diana, A.B.; Cullen, P.J.; Tiwari, B.K.; Ojha, S.K.; Bourke, P.; Álvarez, C.; Rico, D. Effects of dielectric barrier discharge (DBD) generated plasma on microbial reduction and quality parameters of fresh mackerel (Scomber scombrus) fillets. Innov. Food Sci. Emerg. Technol. 2017, 44, 117–122. [Google Scholar] [CrossRef]
- Zou, Z.; Xi, W.; Hu, Y.; Nie, C.; Zhou, Z. Antioxidant activity of citrus fruits. Food Chem. 2016, 196, 885–896. [Google Scholar] [CrossRef]
- Zhang, Q.; Ma, R.; Tian, Y.; Su, B.; Wang, K.; Yu, S.; Zhang, J.; Fang, J. Sterilization efficiency of a novel electrochemical disinfectant against Staphylococcus aureus. Environ. Sci. Technol. 2016, 50, 3184–3192. [Google Scholar] [CrossRef]
- Tarabová, B.; Tampieri, F.; Maran, E.; Marotta, E.; Ostrihoňová, A.; Krewing, M.; Machala, Z. Chemical and antimicrobial effects of air non-thermal plasma processing of fresh apple juice with focus on safety aspects. Foods. 2021, 10, 2055. [Google Scholar] [CrossRef]
- Zhou, R.; Zhou, R.; Wang, P.; Xian, Y.; Mai-Prochnow, A.; Lu, X.; Cullen, P.J.; Ostrikov, K.K.; Bazaka, K. Plasma-activated water: Generation, origin of reactive species and biological applications. J. Phys. D Appl. Phys. 2020, 53, 303001. [Google Scholar] [CrossRef]
- Bruggeman, P.J.; Kushner, M.J.; Locke, B.R.; Gardeniers, J.G.E.; Graham, W.G.; Graves, D.B.; Hofman-Caris, R.C.H.M.; Maric, D.; Reid, J.P.; Ceriani, E. Plasma–liquid interactions: A review and roadmap. Plasma Sources Sci. Technol. 2016, 25, 053002. [Google Scholar] [CrossRef]
- Hadinoto, K.; Astorga, J.B.; Masood, H.; Zhou, R.; Alam, D.; Cullen, P.J.; Prescott, S.; Trujillo, F.J. Efficacy optimization of plasma-activated water for food sanitization through two reactor design configurations. Innov. Food Sci. Emerg. Technol. 2021, 74, 102867. [Google Scholar] [CrossRef]
- Suwal, S.; Coronel-Aguilera, C.P.; Auer, J.; Applegate, B.; Garner, A.L.; Huang, J. Mechanism characterization of bacterial inactivation of atmospheric air plasma gas and activated water using bioluminescence technology. Innov. Food Sci. Emerg. Technol. 2019, 53, 18–25. [Google Scholar] [CrossRef]
- Bai, I.; Muhammad, A.I.; Hu, Y.; Koseki, S.; Liao, X.; Chen, S.; Ye, X.; Liu, D.; Ding, T. Inactivation kinetics of Bacillus cereus spores by plasma activated water (PAW). Food Res. Int. 2020, 131, 109041. [Google Scholar] [CrossRef]
- Park, I.Y.; Park, S.; Choe, W.; Yong, H.I.; Jo, C.; Kim, K. Plasma-functionalized solution: A potent antimicrobial agent for biomedical applications from antibacterial therapeutics to biomaterial surface engineering. ACS Appl. Mater. Interfaces 2017, 9, 43470–43477. [Google Scholar] [CrossRef]
- Hojnik, N.; Modic, M.; Ni, Y.; Filipič, G.; Cvelbar, U.; Walsh, J.L. Effective fungal spore inactivation with an environmentally friendly approach based on atmospheric pressure air plasma. Environ. Sci. Technol. 2019, 53, 1893–1904. [Google Scholar] [CrossRef] [PubMed]
- Royintarat, T.; Choi, E.H.; Boonyawan, D.; Seesuriyachan, P.; Wattanutchariya, W. Chemical-free and synergistic interaction of ultrasound combined with plasma-activated water (PAW) to enhance microbial inactivation in chicken meat and skin. Sci. Rep. 2020, 10, 1559. [Google Scholar] [CrossRef] [PubMed]
- Guo, L.; Xu, R.; Gou, L.; Liu, Z.; Zhao, Y.; Liu, D.; Zhang, L.; Chen, H.; Kong, M.G. Mechanism of virus inactivation by cold atmospheric-pressure plasma and plasma-activated water. Appl. Environ. Microbiol. 2018, 84, e00726-18. [Google Scholar] [CrossRef]
- Su, X.; Tian, Y.; Zhou, H.; Li, Y.; Zhang, Z.; Jiang, B.; Yang, B.; Zhang, J.; Fang, J. Inactivation efficacy of nonthermal plasma-activated solutions against Newcastle disease virus. Appl. Environ. Microbiol. 2018, 84, e02836-17. [Google Scholar] [CrossRef]
- Asimakopoulou, E.; Εkonomou, S.Ι.; Papakonstantinou, P.; Doran, O.; Stratakos, A.C. Inhibition of corrosion causing Pseudomonas aeruginosa using plasma-activated water. J. Appl. Microbiol. 2022, 132, 2781–2794. [Google Scholar] [CrossRef]
- Matsui, Y.; Takeuchi, N.; Sasaki, K.; Hayashi, R.; Yasuoka, K. Experimental and theoretical study of acetic-acid decomposition by a pulsed dielectric-barrier plasma in a gas–liquid two-phase flow. Plasma Sources Sci. Technol. 2011, 20, 034015. [Google Scholar] [CrossRef]
- Naghili, H.; Tajik, H.; Mardani, K.; Rouhani, S.M.R.; Ehsani, A.; Zare, P. Validation of drop plate technique for bacterial enumeration by parametric and nonparametric tests. Vet. Res. Forum 2013, 4, 179–183. [Google Scholar] [PubMed]
- Ekonomou, S.I.; Bulut, S.; Karatzas, K.A.G.; Boziaris, I.S. Inactivation of Listeria monocytogenes in raw and hot smoked trout fillets by high hydrostatic pressure processing combined with liquid smoke and freezing. Innov. Food Sci. Emerg. Technol. 2020, 64, 102427. [Google Scholar] [CrossRef]
- Ziuzina, D.; Patil, S.; Cullen, P.J.; Keener, K.M.; Bourke, P. Atmospheric cold plasma inactivation of Escherichia coli, Salmonella enterica serovar Typhimurium and Listeria monocytogenes inoculated on fresh produce. Food Microbiol. 2014, 42, 109–116. [Google Scholar] [CrossRef] [PubMed]
- Phan, K.T.K.; Phan, H.T.; Brennan, C.S.; Regenstein, J.M.; Jantanasakulwong, K.; Boonyawan, D.; Phimolsiripol, Y. Gliding arc discharge non-thermal plasma for retardation of mango anthracnose. LWT-Food Sci. Technol. 2019, 105, 142–148. [Google Scholar] [CrossRef]
- Bojanowska-Czajka, A.; Nichipor, H.; Drzewicz, P.; Szostek, B.; Gałęzowska, A.; Męczyńska, S.; Kruszewski, M.; Zimek, Z.; Nałęcz-Jawecki, G.; Trojanowicz, M. Radiolytic decomposition of pesticide carbendazim in waters and wastes for environmental protection. J. Radioanal. Nucl. Chem. 2011, 289, 303–314. [Google Scholar] [CrossRef]
- Gavahian, M.; Meng-Jen, T.; Khaneghah, A.M. Emerging techniques in food science: The resistance of chlorpyrifos pesticide pollution against arc and dielectric barrier discharge plasma. Qual. Assur. Saf. Crops Foods. 2020, 12, 9–17. [Google Scholar] [CrossRef]
- Wang, S.; Wang, J.; Wang, T.; Li, C.; Wu, Z. Effects of ozone treatment on pesticide residues in food: A review. Int. J. Food Sci. Technol. 2019, 54, 301–312. [Google Scholar] [CrossRef]
- Calvo, H.; Redondo, D.; Remón, S.; Venturini, M.E.; Arias, E. Efficacy of electrolyzed water, chlorine dioxide and photocatalysis for disinfection and removal of pesticide residues from stone fruit. Postharvest Biol. Technol. 2019, 148, 22–31. [Google Scholar] [CrossRef]
- Yehia, S.; Petrea, N.; Grigoriu, N.; Vizireanu, S.; Zarif, M.E.; Carpen, L.G.; Ginghina, R.; Dinescu, G. Organophosphorus toxic compounds degradation in aqueous solutions using single filament dielectric barrier discharge plasma jet source. J. Water Process Eng. 2022, 46, 102637. [Google Scholar] [CrossRef]
- Codex Alimentarius. 72-Carbendazim. Available online: https://www.fao.org/fao-who-codexalimentarius/codex-texts/dbs/pestres/pesticide-detail/en/?p_id=72 (accessed on 8 July 2022).
- Ali, M.; Cheng, J.; Sun, D. Effect of plasma activated water and buffer solution on fungicide degradation from tomato (Solanum lycopersicum) fruit. Food Chem. 2021, 350, 129195. [Google Scholar] [CrossRef]
- Codex Alimentarius. 17-Chlorpyrifos. Available online: https://www.fao.org/fao-who-codexalimentarius/codex-texts/dbs/pestres/pesticide-detail/en/?p_id=17 (accessed on 8 July 2022).
- Sarangapani, C.; Patange, A.; Bourke, P.; Keener, K.; Cullen, P.J. Recent advances in the application of cold plasma technology in foods. Annu. Rev. Food Sci. Technol. 2018, 9, 609–629. [Google Scholar] [CrossRef] [PubMed]
- Gavahian, M.; Sarangapani, C.; Misra, N.N. Cold plasma for mitigating agrochemical and pesticide residue in food and water: Similarities with ozone and ultraviolet technologies. Food Res. Int. 2021, 141, 110138. [Google Scholar] [CrossRef]
- Mošovská, S.; Medvecká, V.; Klas, M.; Kyzek, S.; Valík, L.; Mikulajová, A.; Zahoranová, A. Decontamination of Escherichia coli on the surface of soybean seeds using plasma activated water. LWT-Food Sci. Technol. 2022, 154, 112720. [Google Scholar] [CrossRef]
- Wang, Q.; Salvi, D. Evaluation of plasma-activated water (PAW) as a novel disinfectant: Effectiveness on Escherichia coli and Listeria innocua, physicochemical properties, and storage stability. LWT Food Sci. Technol. 2021, 149, 111847. [Google Scholar] [CrossRef]
- Xiang, Q.; Kang, C.; Niu, L.; Zhao, D.; Li, K.; Bai, Y. Antibacterial activity and a membrane damage mechanism of plasma-activated water against Pseudomonas deceptionensis CM2. LWT Food Sci. Technol. 2018, 96, 395–401. [Google Scholar] [CrossRef]
- Santos, L.C.O.; Cubas, A.L.V.; Moecke, E.H.S.; Ribeiro, D.H.B.; Amante, E.R. Use of cold plasma to inactivate Escherichia coli and physicochemical evaluation in pumpkin puree. J. Food Prot. 2018, 81, 1897–1905. [Google Scholar] [CrossRef]
- Kashmiri, Z.N.; Mankar, S.A. Free radicals and oxidative stress in bacteria. Int. J. Curr. Microbiol. Appl. Sci. 2014, 3, 34–40. [Google Scholar]
- Thirumdas, R.; Kothakota, A.; Annapure, U.; Siliveru, K.; Blundell, R.; Gatt, R.; Valdramidis, V.P. Plasma activated water (PAW): Chemistry, physico-chemical properties, applications in food and agriculture. Trends Food Sci. Technol. 2018, 77, 21–31. [Google Scholar] [CrossRef]
- Laurita, R.; Gozzi, G.; Tappi, S.; Capelli, F.; Bisag, A.; Laghi, G.; Gherardi, M.; Cellini, B.; Abouelenein, D.; Vittori, S.; et al. Effect of plasma activated water (PAW) on rocket leaves decontamination and nutritional value. Innov. Food Sci. Emerg. Technol. 2021, 73, 102805. [Google Scholar] [CrossRef]
- Sammanee, P.; Ngamsanga, P.; Jainonthee, C.; Chupia, V.; Sawangrat, C.; Kerdjana, W.; Na Lampang, K.; Meeyam, T.; Pichpol, D. Decontamination of pathogenic and spoilage bacteria on pork and chicken meat by liquid plasma immersion. Foods. 2022, 11, 1743. [Google Scholar] [CrossRef]
- Alenyorege, E.A.; Ma, H.; Ayim, I.; Zhou, C.; Wu, P.; Hong, C.; Osae, R. Effect of multi-frequency ultrasound surface washing treatments on Escherichia coli inactivation and some quality characteristics of non-heading Chinese cabbage. J. Food Process. Preserv. 2018, 42, e13747. [Google Scholar] [CrossRef]
- Barba, F.J.; Koubaa, M.; Prado-Silva, L.D.; Orlien, V.; Sant’Ana, A.d.S. Mild processing applied to the inactivation of the main foodborne bacterial pathogens: A review. Trends Food Sci. Technol. 2017, 66, 20–35. [Google Scholar] [CrossRef]
- Wang, Y.; Li, B.; Shang, H.; Ma, R.; Zhu, Y.; Yang, X.; Ju, S.; Zhao, W.; Sun, H.; Zhuang, J.; et al. Effective inhibition of fungal growth, deoxynivalenol biosynthesis and pathogenicity in cereal pathogen Fusarium spp. by cold atmospheric plasma. Chem. Eng. J. 2022, 437, 135307. [Google Scholar] [CrossRef]
- Go, S.; Park, M.; Kim, S.; Choi, W.S.; Jeong, R. Antifungal effect of non-thermal atmospheric plasma and its application for control of postharvest Fusarium oxysporum decay of paprika. Food Control 2019, 98, 245–252. [Google Scholar] [CrossRef]
- Thirumdas, R.; Sarangapani, C.; Annapure, U.S. Cold plasma: A novel non-thermal technology for food processing. Food Biophys. 2015, 10, 1–11. [Google Scholar] [CrossRef]
- Ong, M.K.; Kazi, F.K.; Forney, C.F.; Ali, A. Effect of gaseous ozone on papaya anthracnose. Food Bioproc. Technol. 2013, 6, 2996–3005. [Google Scholar] [CrossRef]
- Ochoa-Velasco, C.E.; Pérez-Pérez, J.C.; Varillas-Torres, J.M.; Navarro-Cruz, A.R.; Hernández-Carranza, P.; Munguía-Pérez, R.; Cid-Pérez, T.S.; Avila-Sosa, R. Starch edible films/coatings added with carvacrol and thymol: In vitro and in vivo evaluation against Colletotrichum gloeosporioides. Foods 2020, 10, 175. [Google Scholar] [CrossRef]
- Phimolsiripol, Y.; Buadoktoom, S.; Leelapornpisid, P.; Jantanasakulwong, K.; Seesuriyachan, P.; Chaiyaso, T.; Leksawasdi, N.; Rachtanapun, P.; Chaiwong, N.; Sommano, S.R.; et al. Shelf life extension of chilled pork by optimal ultrasonicated ceylon spinach (Basella alba) extracts: Physicochemical and Microbial Properties. Foods 2021, 10, 1241. [Google Scholar] [CrossRef]
- Phan, K.K.T.; Phan, H.T.; Uthaichana, K.; Phimolsiripol, Y. Effect of non-thermal plasma on physicochemical properties of Nam Dok Mai mango. Int. J. Adv. Sci. Eng. Inf. Technol. 2017, 7, 263–268. [Google Scholar] [CrossRef]

Publisher’s Note: MDPI stays neutral with regard to jurisdictional claims in published maps and institutional affiliations. |
© 2022 by the authors. Licensee MDPI, Basel, Switzerland. This article is an open access article distributed under the terms and conditions of the Creative Commons Attribution (CC BY) license (https://creativecommons.org/licenses/by/4.0/).
Share and Cite
Sawangrat, C.; Phimolsiripol, Y.; Leksakul, K.; Thanapornpoonpong, S.-n.; Sojithamporn, P.; Lavilla, M.; Castagnini, J.M.; Barba, F.J.; Boonyawan, D. Application of Pinhole Plasma Jet Activated Water against Escherichia coli, Colletotrichum gloeosporioides, and Decontamination of Pesticide Residues on Chili (Capsicum annuum L.). Foods 2022, 11, 2859. https://doi.org/10.3390/foods11182859
Sawangrat C, Phimolsiripol Y, Leksakul K, Thanapornpoonpong S-n, Sojithamporn P, Lavilla M, Castagnini JM, Barba FJ, Boonyawan D. Application of Pinhole Plasma Jet Activated Water against Escherichia coli, Colletotrichum gloeosporioides, and Decontamination of Pesticide Residues on Chili (Capsicum annuum L.). Foods. 2022; 11(18):2859. https://doi.org/10.3390/foods11182859
Chicago/Turabian StyleSawangrat, Choncharoen, Yuthana Phimolsiripol, Komgrit Leksakul, Sa-nguansak Thanapornpoonpong, Phanumas Sojithamporn, Maria Lavilla, Juan Manuel Castagnini, Francisco J. Barba, and Dheerawan Boonyawan. 2022. "Application of Pinhole Plasma Jet Activated Water against Escherichia coli, Colletotrichum gloeosporioides, and Decontamination of Pesticide Residues on Chili (Capsicum annuum L.)" Foods 11, no. 18: 2859. https://doi.org/10.3390/foods11182859
APA StyleSawangrat, C., Phimolsiripol, Y., Leksakul, K., Thanapornpoonpong, S.-n., Sojithamporn, P., Lavilla, M., Castagnini, J. M., Barba, F. J., & Boonyawan, D. (2022). Application of Pinhole Plasma Jet Activated Water against Escherichia coli, Colletotrichum gloeosporioides, and Decontamination of Pesticide Residues on Chili (Capsicum annuum L.). Foods, 11(18), 2859. https://doi.org/10.3390/foods11182859

